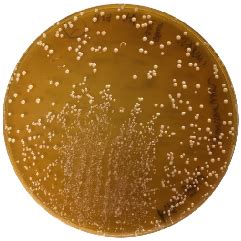
Colonie di Lactobacillus su terreno MRS agar
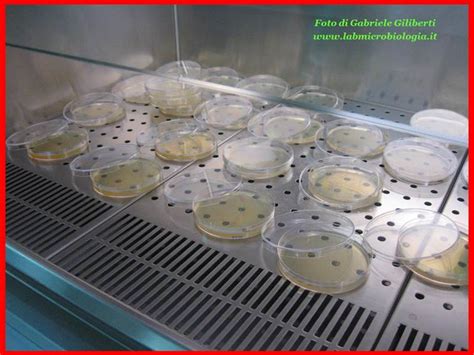
Incubazione delle piastre Petri
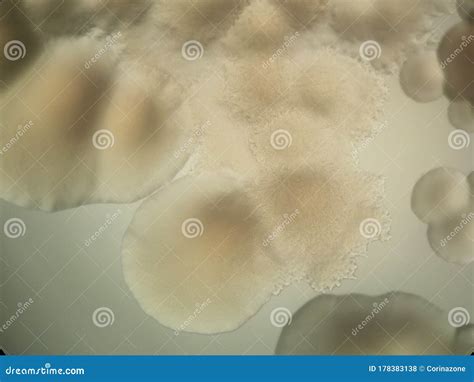
Microscopia di colonie di Lactobacillus

Il terreno di coltura MRS agar, identificato con il codice NCM0190, è uno strumento fondamentale nello studio dei batteri lattici, sviluppato specificamente per la loro enumerazione secondo la norma ISO 15214:1998. È importante sottolineare che questo terreno non è destinato alla diagnostica di patologie umane.
La sua ideazione risale al 1960, ad opera di de Man, Rogosa e Sharpe, con l'obiettivo primario di facilitare il conteggio di Lactobacillus spp. in diverse matrici, come ad esempio nel succo di pomodoro. La norma ISO 15214:1998 richiede che il terreno presenti un pH di 5,7, pertanto la formula originale è stata oggetto di modifiche per raggiungere questo valore.
Composizione e Preparazione del Terreno MRS
L'efficacia nutrizionale del terreno MRS è garantita da una combinazione di ingredienti chiave: digerito enzimatico di caseina, glucosio, estratto di carne ed estratto di lievito. La crescita dei microrganismi è stimolata dalla presenza di poliossietilenesorbitano monooleato, magnesio e manganese fosfato.
La selettività del terreno, fondamentale per inibire la crescita di streptococchi e muffe, è conferita dal sodio citrato e dall’ammonio solfato. Quest'ultimo, in particolare, gioca un ruolo cruciale a bassi valori di pH, favorendo la proliferazione dei lattobacilli ma limitando quella di molti altri tipi di microrganismi.
Formula del Terreno MRS Agar (per litro)
| Ingrediente | Quantità (g/l) |
|---|---|
| Digerito enzimatico di caseina | 10,00 |
| Estratto di carne | 10,00 |
| Estratto di lievito | 4,00 |
| Citrato triammonico | 2,00 |
| Acetato di sodio | 5,00 |
| Manganese solfato tetraidrato | 0,05 |
| Magnesio solfato eptaidrato | 0,20 |
| Dipotassio idrogeno fosfato | 2,00 |
| Glucosio | 20,00 |
| Poliossietilenesorbitano Monooleato | 1,08 |
| Agar | 15,5 |
La preparazione del terreno richiede una serie di passaggi precisi:
- Sospendere 70 g di polvere in 1 litro di acqua pura.
- Riscaldare fino all'ebollizione, mescolando costantemente per sciogliere eventuali grumi.
- Sterilizzare in autoclave a 121°C per 15 minuti.
- Lasciare raffreddare il terreno fino a una temperatura di 45-50°C prima dell'uso.
È fondamentale notare che il processo di sterilizzazione a 121°C può talvolta causare uno scostamento del pH dal valore ottimale di 5,7. In tali circostanze, è possibile correggere il pH aggiungendo poche gocce di acido acetico o idrossido di sodio.

Metodo di Utilizzo e Risultati Attesi
Per l'utilizzo del terreno MRS agar, è necessario inoculare 1 ml di campione, preferibilmente attraverso il metodo delle diluizioni seriali, nella piastra Petri. Successivamente, si aggiunge l'agar fuso, si mescola delicatamente e si attende la solidificazione del terreno. In alternativa, è permessa l'inoculazione superficiale del campione senza incorporarlo nel terreno di coltura.
In entrambi i casi, le piastre devono essere incubate a 30°C per 72 ± 3 ore in condizioni di aerobiosi. L'interpretazione dei risultati ottenuti deve essere condotta in conformità con le indicazioni fornite dalle norme ISO correlate, in particolare la ISO 15214:1998.
Limitazioni del Terreno MRS Agar
Nonostante la sua efficacia, il terreno MRS agar presenta alcune limitazioni. Alcuni microrganismi, a causa delle loro specifiche esigenze nutrizionali, potrebbero manifestare una crescita ridotta o assente sul terreno. Inoltre, sebbene il terreno sia stato concepito per essere selettivo verso i Lattobacilli, è possibile osservare lo sviluppo di alcuni ceppi di Leuconostoc spp. e Pediococci.
Come già accennato, il processo di sterilizzazione in autoclave può occasionalmente indurre un leggero viraggio del pH rispetto al valore target di 5,7. In queste rare situazioni, una correzione tramite l'aggiunta di acido acetico o idrossido di sodio può ripristinare le condizioni ottimali.
Lezione 1 "Analisi del terreno: il campionamento" by profvaldi
Controllo Qualità
Per garantire l'affidabilità dei risultati, è essenziale effettuare un controllo qualità del terreno MRS agar. L'aspetto della polvere deve essere fine, leggermente coesivo e di colore beige chiaro. Una volta preparato, il terreno solido deve presentarsi privo di grumi, liscio e di colore beige chiaro.
I microrganismi comunemente utilizzati per verificare la crescita e la funzionalità del terreno includono:
- Lactobacillus sakei subsp. sakei WDCM 00015
- Lactococcus lactis subsp. lactis WDCM 00016
Al contrario, per confermare la selettività del terreno, si utilizza Escherichia coli WDCM 00013, il quale dovrebbe risultare completamente inibito e non mostrare alcuna crescita.
tags: #terreno #di #coltura #lactobacillus